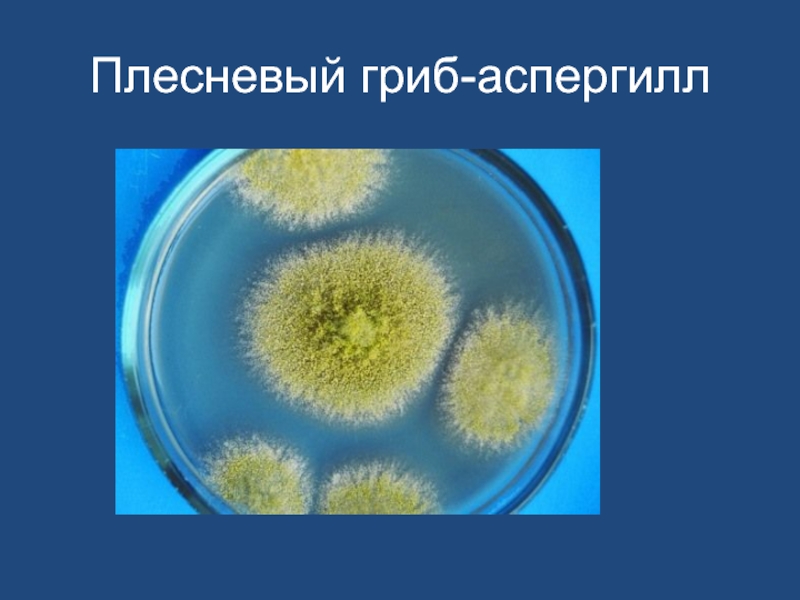

- Главная
- Разное
- Образование
- Спорт
- Естествознание
- Природоведение
- Религиоведение
- Французский язык
- Черчение
- Английский язык
- Астрономия
- Алгебра
- Биология
- География
- Геометрия
- Детские презентации
- Информатика
- История
- Литература
- Математика
- Музыка
- МХК
- Немецкий язык
- ОБЖ
- Обществознание
- Окружающий мир
- Педагогика
- Русский язык
- Технология
- Физика
- Философия
- Химия
- Шаблоны, фоны, картинки для презентаций
- Экология
- Экономика
Презентация, доклад на тему 8 класс. Урок по биологии на тему Грибы
Содержание
- 1. 8 класс. Урок по биологии на тему Грибы
- 2. Цель урока: 1.Сформировать знания об отличительных признаках
- 3. «Если положить на
- 4. Признаки грибов
- 5. Слайд 5
- 6. Микология –наука о грибах Греческое слово
- 7. Задания 1- ой инструктивной карточки1.Назовите представителей
- 8. Задания 2- ой инструктивной карточки1. Рассмотрите белую
- 9. Задания 3- ей инструктивной карточки1. Рассмотрите строение
- 10. Критерии оценивания 1.Знать отличительные признаки грибов2. Знать
- 11. Знаешь ли ты биологические термины
- 12. Признаки грибов
- 13. Строение шляпочного гриба
- 14. Плесневые грибы –пеницилл-синяя плесень
- 15. Плесневые грибы-мукор «белая плесень»
- 16. Плесневый гриб-аспергилл
- 17. Слайд 17
- 18. Роль грибов в природе и в жизни человека
- 19. Роль грибов
- 20. Результаты опыта : «Влияние фитонцидов на появление плесени»
- 21. Исследование плесени Изучение условий, необходимых для возникновения
- 22. Изучение условий необходимых для возникновения
- 23. Результаты опыта на 3 день
- 24. Результаты опыта на 5-ый день
- 25. Результаты опыта на 9 ый день
- 26. Микориза-сожительство гриба с деревьями
Цель урока: 1.Сформировать знания об отличительных признаках грибов2.Ознакомится с основными группами грибов3.Ознакомится со строением ,жизнедеятельностью и размножением шляпочных,плесневых и дрожжевых грибов 4.Ознакомится с ролью грибов в природе и в жизни человека 5.Уметь применять знания в жизни
Слайд 2Цель урока:
1.Сформировать знания об отличительных признаках грибов
2.Ознакомится с основными группами
грибов
3.Ознакомится со строением ,жизнедеятельностью и размножением шляпочных,плесневых и дрожжевых грибов
4.Ознакомится с ролью грибов в природе и в жизни человека
5.Уметь применять знания в жизни
3.Ознакомится со строением ,жизнедеятельностью и размножением шляпочных,плесневых и дрожжевых грибов
4.Ознакомится с ролью грибов в природе и в жизни человека
5.Уметь применять знания в жизни
Слайд 3 «Если положить на чаши весов полезную и вредную для
человека деятельность грибов ,то весы примерно уравновесятся»
М.В .Горленко
.В Горленко
Слайд 6Микология –наука о грибах
Греческое слово «микос »-гриб
«логос»-наука
Основоположник микологии-
Генрих Антон Бари
Слайд 7Задания 1- ой инструктивной карточки
1.Назовите представителей шляпочных грибов
2. . Рассмотрите
плодовые тела шляпочных грибов, найдите основные части гриба: пенек(ножка) и шляпку .Зарисуйте в тетради шляпочный гриб,укажите шляпку,ножку и грибницу .
3.Используя учебник и дополнительный ресурс, обьясните как размножаются шляпочные грибы .
4. Дайте определение термину –микориза
5. Значение шляпочных грибов в природе и в жизни человека
3.Используя учебник и дополнительный ресурс, обьясните как размножаются шляпочные грибы .
4. Дайте определение термину –микориза
5. Значение шляпочных грибов в природе и в жизни человека
Слайд 8Задания 2- ой инструктивной карточки
1. Рассмотрите белую плесень (мукор) на хлебе
невооруженным глазом и при помощи микроскопа . Найдите грибницу и плодовые тела,споры
2. Опишите размножение плесневых грибов
3. Используйте учебник и дополнительный ресурс зарисуйте мукор в тетради и подпишите названия его основных частей.
4.Назовите представителей плесневых грибов
5.Какое значение имеют плесневые грибы .Меры борьбы с плесенью .
2. Опишите размножение плесневых грибов
3. Используйте учебник и дополнительный ресурс зарисуйте мукор в тетради и подпишите названия его основных частей.
4.Назовите представителей плесневых грибов
5.Какое значение имеют плесневые грибы .Меры борьбы с плесенью .
Слайд 9Задания 3- ей инструктивной карточки
1. Рассмотрите строение дрожжевого гриба используя учебник
и дополнительный ресурс ?
2.Зарисуйте клетку дрожжевого гриба ?Укажите составные части клетки .
3. Питание дрожжей ,брожение .Почему их называют сахаромицетами ?
4. Как размножаются дрожжи ?
5.Где используются дрожжевые грибы ?
4. Как размножаются дрожжи ?
5.Где используются дрожжевые грибы ?
Слайд 10Критерии оценивания
1.Знать отличительные признаки грибов
2. Знать основные группы грибов
3.Уметь
описывать строение ,жизнедеятельность ,размножение шляпочных ,плесневых,дрожжевых грибов.
4.Уметь перечислять роль грибов в природе и в жизни человека .
5.Уметь применять знания в жизни
4.Уметь перечислять роль грибов в природе и в жизни человека .
5.Уметь применять знания в жизни
Слайд 21Исследование плесени
Изучение условий, необходимых для возникновения плесени.
ОПЫТ №1
Мы поместили
в три разных контейнера кусочки с черным хлебом
Первый контейнер - влажный; тепло
Второй контейнер - сухой; тепло
Третий контейнер – влажный, холод
Первый контейнер - влажный; тепло
Второй контейнер - сухой; тепло
Третий контейнер – влажный, холод